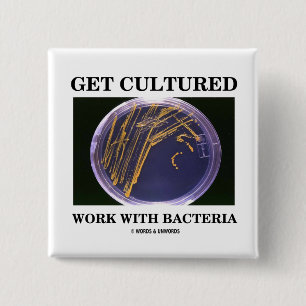
Erhalten Sie kultivierte Arbeit mit Bakterien Button

Beliebte Bakterien Buttons
75 Ergebnisse
Gute Bakterien, schlechte Bakterien Button
Preis4,05 €
Bakterien-Mikroben Button
Preis3,20 €
Bakterien-Phagozytose Button
Preis6,05 €
Spiel mit Bakterien Button
Preis6,05 €
Bakterien Button
Preis6,05 €
Coronavirus Button
Preis3,80 €
MRSA Überfahrt-Zeichen Button
Preis2,85 €
Grüne Mikrobe Button
Preis4,55 €
Biologie Button
Preis4,25 €
Mikrobenimposter-Knopf Button
Preis3,05 €
Hände waschen button
Preis4,15 €
Bakteriologin Scientist Button
Preis4,25 €
Liebliche Germs - Button
Preis4,25 €
Fronteria Bacteria Funny Biology Pub Button
Preis4,75 €
Liebe als Mikrobiologe Button
Preis4,25 €
COVID-19 BUTTON
Preis9,80 €
Kabeljau-19 Button
Preis4,55 €
Bac-atcha Funny Bacteria Pun Button
Preis4,75 €
Bac Bone Funny Bacteria Pub Button
Preis4,75 €
Gelbe Cartoon-Mikrobe Button
Preis4,55 €
Bac Bone Funny Bacteria Pub Dark BG Button
Preis4,75 €
B Cereus Funny Bacteria Pun Dark BG Button
Preis4,75 €
Bac-atcha Funny Bacteria Pun Dark BG Button
Preis4,75 €
Hände waschen button
Preis4,25 €
Grüne u. rosa Cartoon-Mikrobe Button
Preis4,55 €
Bakterielle Freunde Button
Preis6,05 €
Uns gelassen Cellebrate Button
Preis6,05 €
Adios-Amöben Button
Preis6,05 €
Tuberkulose Button
Preis6,05 €
MRSA BUTTON
Preis6,05 €
Deutsches Sprichwort - Retro Button
Preis4,25 €
Gelassen uns streifen button
Preis6,05 €
Darmkrankheit Darmkrankheit Button
Preis5,55 €
Petrischalen-Turm Button
Preis6,05 €
Petrischale MRSA Button
Preis6,05 €
Kultur-Flasche Button
Preis6,05 €
Bakterien-Flagella Button
Preis4,25 €
Bakterien-Tapete Button
Preis4,55 €
Bakterien-Tapete Button
Preis4,55 €
Gib' uns Feedback!
Wenn du Hilfe benötigst oder eine Frage an unseren Kundendienst hast, besuche bitte unser Hilfecenter.
Zuletzt angesehene Produkte